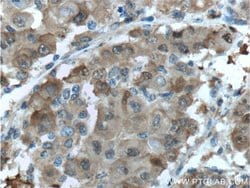
PGD Rabbit anti-Human, Mouse, Rat, Polyclonal, Proteintech 150 &mu;L; Unconjugated:Antibodies,

missing translation for 'onlineSavingsMsg'
Learn More
Learn More
PGD Rabbit anti-Human, Mouse, Rat, Polyclonal, Proteintech
Rabbit Polyclonal Antibody
Brand: Proteintech 14718-1-AP-150UL
This item is not returnable.
View return policy
Description
6-phosphogluconate dehydrogenase is the second dehydrogenase in the pentose phosphate shunt. Deficiency of this enzyme is generally asymptomatic, and the inheritance of this disorder is autosomal domit. Hemolysis results from combined deficiency of 6-phosphogluconate dehydrogenase and 6-phosphogluconolactonase suggesting a synergism of the two enzymopathies.Specifications
| PGD | |
| Polyclonal | |
| Unconjugated | |
| PGD | |
| 6PGD, PGD, PGDH, phosphogluconate dehydrogenase | |
| Rabbit | |
| Antigen Affinity Chromatography | |
| RUO | |
| 100360180, 110208, 5226 | |
| -20°C | |
| Liquid |
| Immunocytochemistry, Immunofluorescence, Immunohistochemistry (Paraffin), Immunoprecipitation, Western Blot | |
| 0.13 mg/mL | |
| PBS with 50% glycerol and 0.02% sodium azide; pH 7.3 | |
| P52209, P85968, Q9DCD0 | |
| PGD | |
| PGD Fusion Protein Ag6444 | |
| 150 μL | |
| Primary | |
| Human, Mouse, Rat | |
| Antibody | |
| IgG |
Product Content Correction
Your input is important to us. Please complete this form to provide feedback related to the content on this product.
Product Title
Spot an opportunity for improvement?Share a Content Correction